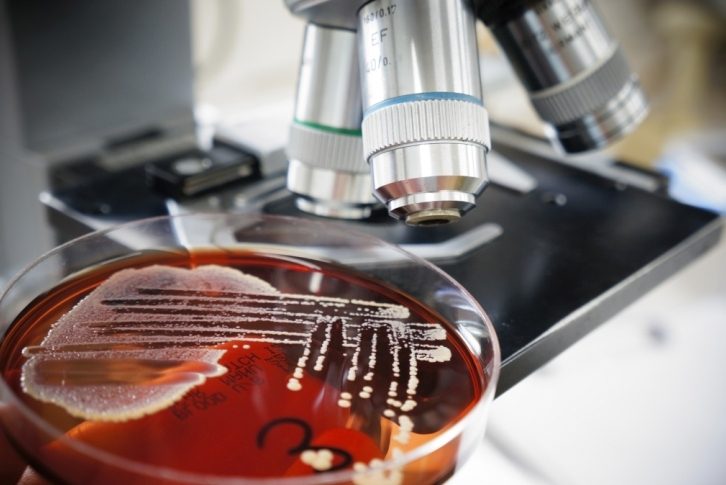
shutterstock_105764732resize

In order to feed our pipeline of innovative products, we are engaged in several technical and scientific collaborations with major industrial and academic partners, at both local (Lille’s Nutrition Health Longevity Cluster) and international levels. Through these partnerships, we have access to all the resources and expertise (microbiology, biochemistry, physiology…) required to carry out ambitious research projects.
COLLABORATIVE PROJECTS

PROBIOTIC RESEARCH
The benefits of probiotics (health-supporting bacteria) on immune and intestinal functions are well established. Our research projects are aimed at identifying new probiotic strains for specific, innovative applications such as prevention and treatment of cardiovascular diseases, metabolic disorders, osteoporosis. Our work involve screening of proprietary bacterial collections, strain characterization, identification of active molecules, pre-clinical evaluation of strain efficacy.
CLINICAL VALIDATION STUDIES

We make a point of launching on the market only ingredients and finished products whose efficacy has been clinically demonstrated. Thanks to our network and academic partnerships, we can perform clinical studies to provide the proof of our product value.





